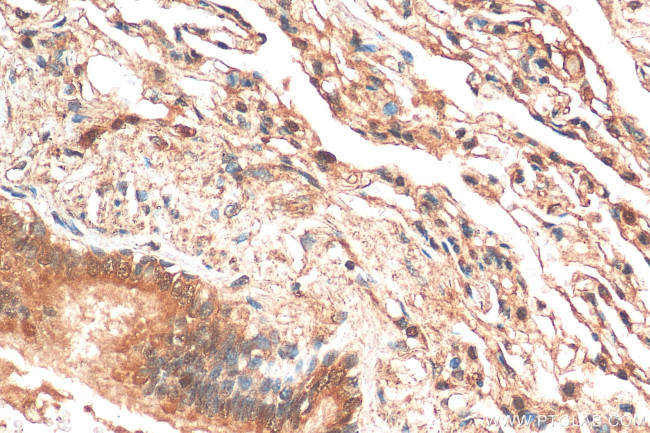
NFATC4 Antibody in Immunohistochemistry (Paraffin) (IHC (P))

Search
Proteintech
NFATC4 Polyclonal Antibody
{{$productOrderCtrl.translations['antibody.pdp.commerceCard.promotion.promotions']}}
{{$productOrderCtrl.translations['antibody.pdp.commerceCard.promotion.viewpromo']}}
{{$productOrderCtrl.translations['antibody.pdp.commerceCard.promotion.promocode']}}: {{promo.promoCode}} {{promo.promoTitle}} {{promo.promoDescription}}. {{$productOrderCtrl.translations['antibody.pdp.commerceCard.promotion.learnmore']}}
产品信息
26311-1-AP
种属反应
宿主/亚型
分类
类型
抗原
偶联物
形式
浓度
规格
纯化类型
保存液
内含物
保存条件
运输条件
产品详细信息
Immunogen sequence: GAGGAGGGRV LECPSIRITS ISPTPEPPAA LEDNPDAWGD GSPRDYPPPE GFGGYREAGG QGGGAFFSPS PGSSSLSSWS FFSDASDEAA LYAACDEVES ELNEAASRFG LGSPLPSPRA SPRPW
靶标信息
This protein is an adapter or scaffold protein, which participates in the assembly of numerous protein complexes and is involved in several cellular processes such as cell fate determination, cytoskeletal organization, repression of gene transcription, mitosis, cell-cell adhesion, cell differentiation, proliferation and migration.
仅用于科研。不用于诊断过程。未经明确授权不得转售。
篇参考文献 (0)
生物信息学
蛋白别名: NF-AT3; NF-ATc4; Nuclear factor of activated T-cells, cytoplasmic 4; nuclear factor of activated T-cells, cytoplasmic, calcineurin-dependent 4; T-cell transcription factor NFAT3; transcription factor; unnamed protein product
基因别名: NF-AT3; NF-ATC4; NFAT3; NFATC4
UniProt ID: (Human) Q14934
Entrez Gene ID: (Human) 4776